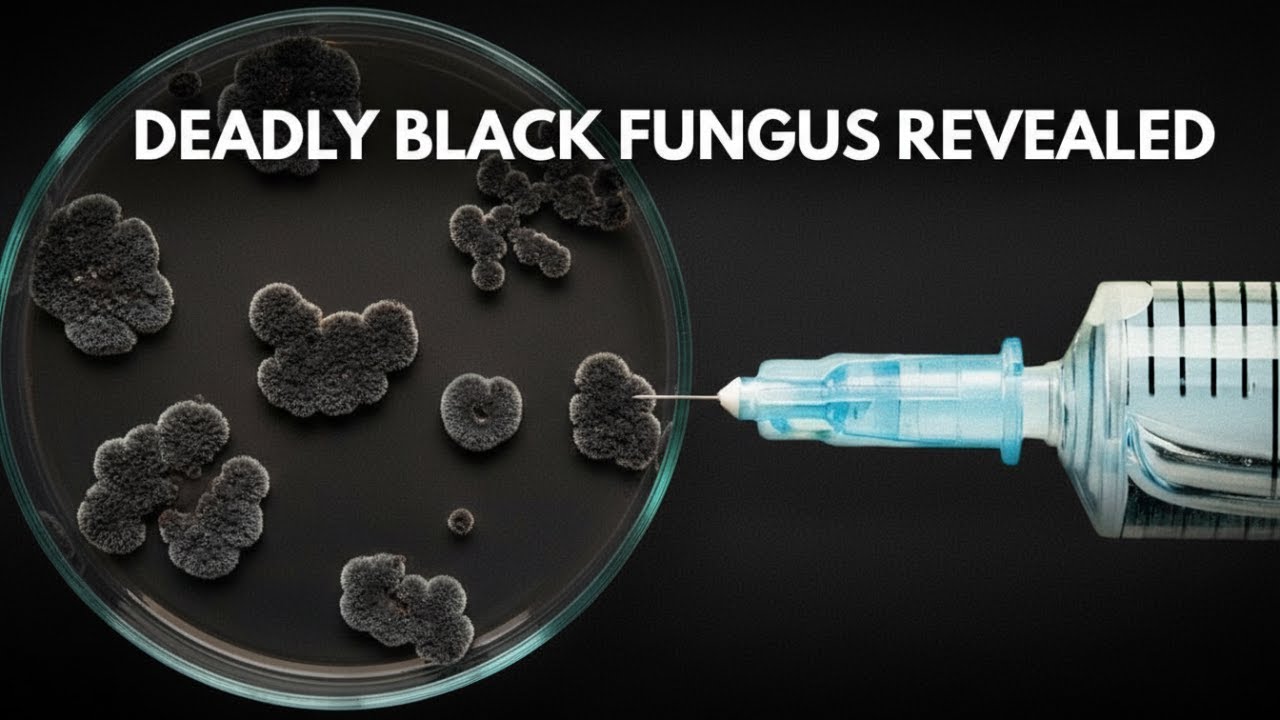

BEWARE of BLACK FUNGUS Post-COVID | Mucormycosis Explained – Causes, Symptoms & Prevention
BEWARE of BLACK FUNGUS Post-COVID | Mucormycosis Explained – Causes, Symptoms & Prevention
India is battling a dangerous and often fatal complication in the wake of COVID-19, especially with the B.1.617 variant: Mucormycosis, or Black Fungus. This rare but aggressive fungal infection is attacking recovered patients with weakened immunity. Understanding this threat could save a life.
In this urgent video, we break down everything you need to know about Mucormycosis—its link to COVID-19, why it’s so deadly, and how to protect yourself and your loved ones.
⚠️ URGENT DISCLAIMER:
This video is for EDUCATIONAL and INFORMATIONAL PURPOSES ONLY. It is NOT a substitute for professional medical advice, diagnosis, or treatment. Mucormycosis is a medical emergency. If you or someone you know has recovered from COVID-19 (especially with diabetes or steroid use) and shows symptoms like facial swelling, blackish nasal discharge, or vision issues, CONSULT A HEALTHCARE PROFESSIONAL IMMEDIATELY.
📖 Detailed Article & Key Points:
INTRODUCTION:
Mucormycosis is a serious opportunistic infection caused by mucormycetes fungi, commonly found in soil, dung, compost, and decaying organic matter. It typically affects people with compromised immune systems, entering via inhalation or skin wounds.
KEY RISK FACTORS (The Perfect Storm):
Recent COVID-19 Infection: The B.1.617 variant and the immune response it triggers can weaken defenses.
Uncontrolled Diabetes: High blood sugar creates an ideal environment for fungal growth.
Excessive Steroid Use: Improper/overuse of steroids (like dexamethasone) for COVID-19 suppresses immunity.
Environmental Exposure: Contact with soil, dust, or contaminated materials.
CONCLUSION & PUBLIC HEALTH STATUS:
Mucormycosis has emerged as a devastating post-COVID complication with high mortality. Due to its severity, it is now a notifiable disease in India under the Epidemic Diseases Act, 1897. Similar trends were observed post-SARS. Prevention is paramount: control blood sugar, use steroids judiciously under medical supervision, avoid direct contact with soil/dust, and maintain strict hygiene. Early awareness and prompt medical intervention are crucial for survival.
🔗 Relevant Hashtags for SEO:
#BlackFungus #Mucormycosis #PostCOVIDComplication #COVID19India #DiabeticAwareness #FungalInfection #HealthWarning #MedicalEducation #OpportunisticInfection #PublicHealth #SteroidUse #Prevention #HealthTips
*🔍 RELATED KEYWORDS*
Mucormycosis, Black Fungus, Black Fungus in India, Post COVID complication, COVID-19 second wave, B.1.617 variant, Opportunistic infection, Fungal infection symptoms, Rhino-orbital cerebral mucormycosis, Diabetes and COVID, Steroid side effects, How to prevent black fungus, Epidemic Diseases Act, Notifiable disease, Health alert, Medical emergency, Mycoses, Environmental fungi, Immune system, Warning signs, Health education, Doctor advice, Save life
//////////////////////////////
Study about Black Fungus: Clinical Manifestation and Treatment
Layman Abstract :
India has faced a surge of the B.1.617 variant of SARS‑COVID‑19, which may weaken the immune system in some patients. This has led to an increase in dangerous fungal infections, especially Mucormycosis, also known as black fungus. Although rare, this infection can be life-threatening. Understanding where these fungi come from and how they infect the body is important for prevention. Raising awareness and helping patients recognize early symptoms can greatly reduce serious complications and save lives.
To read other sections of this article please visit: https://bookstore.bookpi.org